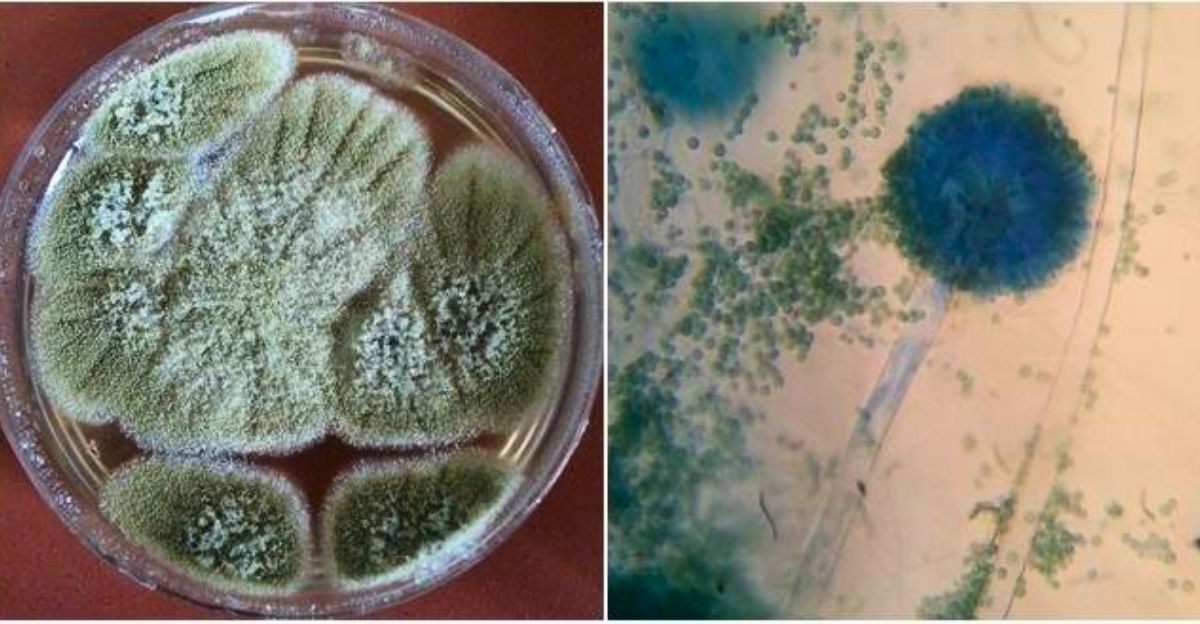
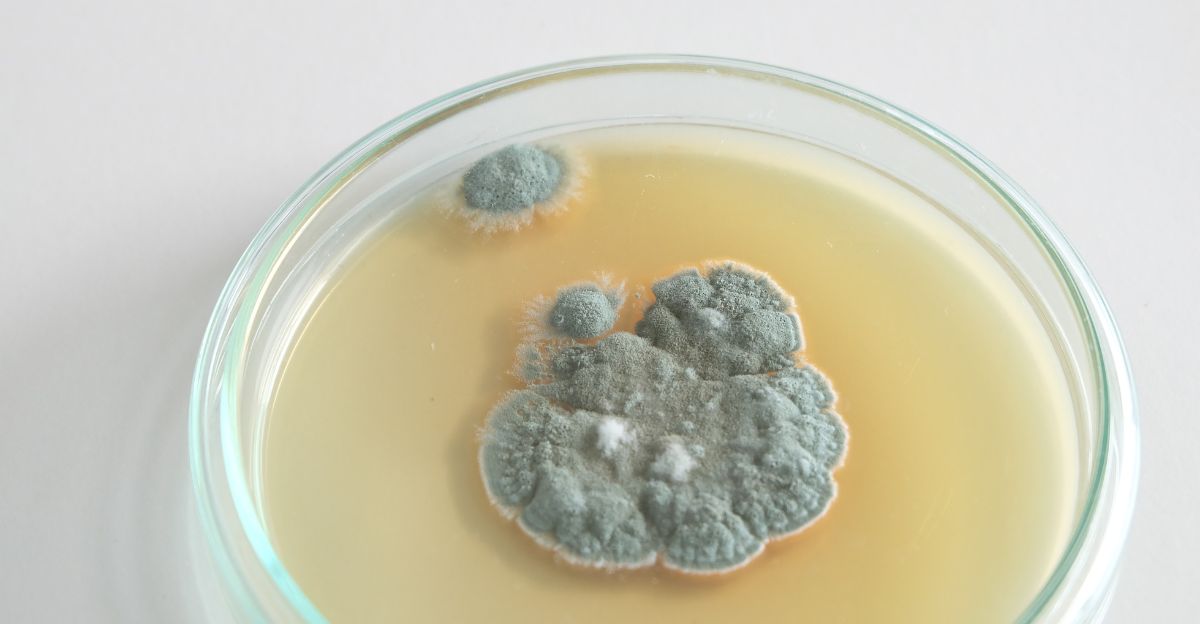

For many years, old tombs in Egypt have been full of mystery and fear. People often talked about a “curse” that killed anyone who explored the pharaohs’ sealed chambers.
Some believed something dangerous was inside, but no one knew what it was. Scientists are learning that what seemed like a curse might help us today.
How could something that once brought death now offer hope?
The People Who Opened History’s Doors

The people who found these tombs were revolutionary Egyptologists, foreign financiers, and their loyal crews.
Most famously, Howard Carter led the British expedition that unearthed King Tutankhamun’s tomb in 1922, with Lord Carnarvon as its principal backer.
Other groups, including some in Poland, dug up royal graves later on. Many risked their lives searching for history, not knowing they could face one of archaeology’s most chilling legends.
The Real “Curse”
The danger came from a fungus called Aspergillus flavus, a naturally occurring mold renowned for its resilience. This mold can grow for hundreds of years in dark, closed spaces like tombs.
When people open the tombs, the fungus spreads tiny spores into the air.
The fungus became known as the ‘Pharaoh’s Curse,’ and it caused mysterious illnesses and deaths among Carter’s generation and later archaeological teams worldwide.
Key Moments in the Legend of the Curse

The pivotal events occurred across two notable periods. The first began in November 1922, when Carter broke through to Tutankhamun’s burial chamber in the Valley of the Kings.
Within months, the rumors of the curse started when many people involved fell ill and even died.
Another event happened in 1973 in Poland, when scientists opened a royal crypt. More people got sick, causing more stories about the curse.
From Egypt to Poland

Most of these moments happened in Egypt’s Valley of the Kings, where Tutankhamun’s and others’ tombs are buried. Yet they also appeared in places where sealed burial chambers have been dug out, like Poland’s Wawel Cathedral.
These spaces are perfect for mold survival because they’re closed up, have some moisture, and contain old food and bodies.
This gave the fungus a safe place to stay alive for centuries.
Why the Fungus Thrived

Aspergillus flavus thrives in dark, damp places and can survive very long. When tombs are opened, the spores float in the air and can enter people’s lungs.
People with weak immune systems are most at risk of developing severe or even fatal pulmonary infections.
At the time, no one understood it was the fungus, so they blamed curses.
Tragedy in the Wake of Discovery

After explorers opened the tombs, some started to die soon after. Lord Carnarvon’s death within months of the Tutankhamun discovery and several others stoked fears and speculation.
In the 1970s, 10 out of 12 researchers entering Casimir IV’s crypt suffered a similar fate.
As Dr. Sherry Gao, one of the key researchers in the field, pointed out years later, “This is nature’s irony at its finest. The same fungus once feared for bringing death may now help save lives.”
Fungus Offers New Hope in Medicine

Recent years saw a dramatic shift in perspective. Scientists have found something amazing in the fungus. It makes special molecules that have demonstrated the ability to destroy leukemia cells in laboratory conditions, showing promise as a new generation of targeted cancer treatments.
As Dr. Gao explained, “Fungi gave us penicillin. These results show that many more medicines derived from natural products remain to be found.”
This means things we once feared could be medicine.
Small Molecules with Big Impacts

The scientists found special parts called RiPPs in the fungus. They changed these molecules a little in their labs and discovered they could stop cancer cells from growing.
“Peptides comprise two or more amino acids linked together by chemical bonds, and amino acids are the cell’s building blocks to synthesize proteins. You can think of RiPPs as mini proteins,” explained Dr. José Larios of the Barbara Ann Karmanos Cancer Institute.
These new compounds worked, as did some current cancer medicines.
Moving from the Tomb to the Test Tube

To change the fungus into something helpful, researchers cultivated strains of the mold, carefully modified their genetics, and evaluated the resulting compounds.
They tested the new molecules on cancer cells and found they worked.
Making these compounds is hard work, but as study co-author Qiuyue Nie noted, “The synthesis of these compounds is complicated. But that’s also what gives them this remarkable bioactivity.”
Fungi Saving Lives
Fungi have given us many medicines, such as penicillin. The story of the tomb fungus is similar as it went from something dangerous to something that could save lives.
Popular Science summarizes this: “Despite its deadly reputation, the fungus contains peptides that can fight cancer when modified.”
The new findings renew hope that many more medicines remain hidden within the world’s microbial diversity, waiting to be discovered and refined for medical use by future generations.
Why This Fungus Matters

Unlike most molds, Aspergillus flavus can endure extreme environmental stress for centuries.
Its ability to remain dormant, coupled with its chemical arsenal, sets it apart as a subject of big interest among microbiologists and medical researchers.
Its dual nature of being poison and possible panacea emphasizes the difficulty and promise of studying ancient pathogens.
Using Ancient Fungi Responsibly

Scientists are cautious when working with this fungus. They ensure it can’t hurt anyone and only use the safe parts for medicine. Labs follow strict rules so no one gets sick.
Ongoing research also seeks to ensure these treatments remain selective for cancer cells, sparing healthy tissues.
What Archaeology Teaches Modern Medicine

This story shows that archaeology is not all fun and games; it can be dangerous.
It also proves how important it is for experts from different fields, such as archaeologists, microbiologists, and medical researchers, to collaborate.
By learning from the past, scientists found hope for the future, turning an old threat into a medical breakthrough.
From Ancient Curses to New Cures

More studies are planned with these discoveries, and new medicines might soon be tested on patients.
What started as a story about old tombs and mystery is now about hope and healing.
The fungus that once brought fear could be the reason many lives are saved in the future.